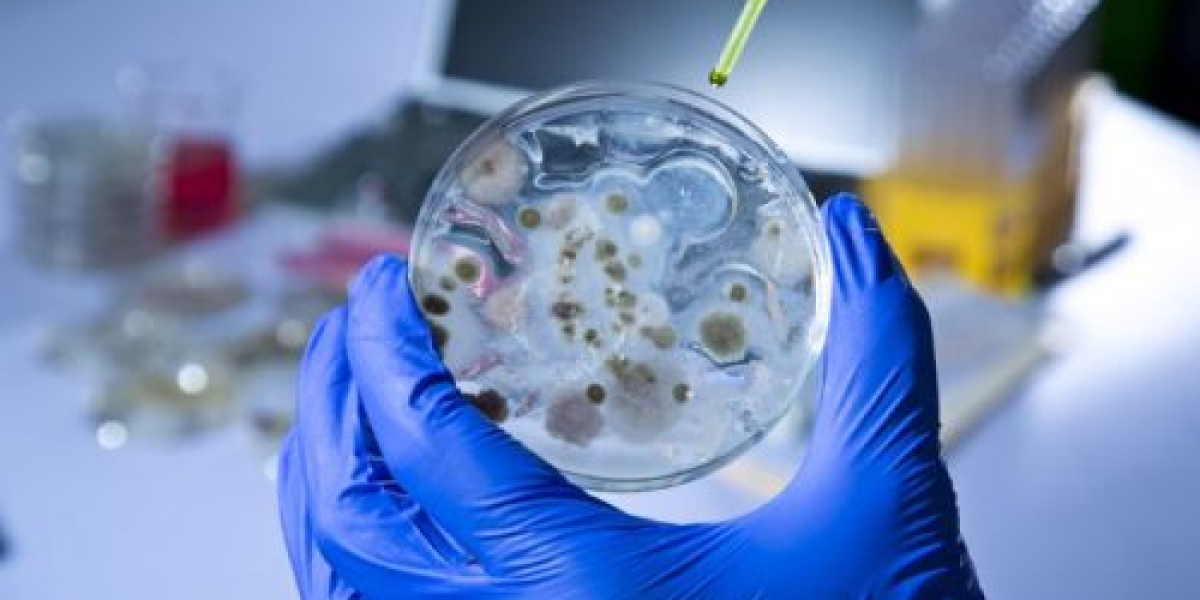
Chlorobenzene Manufacturing Plant Project Report 2023: Manufacturing Process, Plant Setup, Raw Materials, Investment Opp

➢Official Link Page—https://www.facebook.com/ActiveKetoGummiesInIE/
➢Product Name — Active Keto Gummies Ireland
➢Main Benefits — Improve Health & Helps in Lose weight
➢ Composition — Natural Organic Compound
➢ Side-Effects — NA
➢ Rating: — ⭐⭐⭐⭐⭐
➢ Availability — Online
➢Price (for Sale) Buy Now Here —Click Here
What Makes Active Keto Gummies Ireland Perform Weight reduction?
Active Keto Gummies IrelandUK is an essential dietary recipe with dynamic fixings that are useful and fat misfortune. The significant objective is ketosis and that is the thing this dietary recipe really assists you with accomplishing. It's a significant weight reduction supplement bringing you independence from fat capacity forever. It can at the same time give better protection from insulin and hunger control. The pretend of best keto equation is extremely powerful for person. Notwithstanding, you can't expect same outcomes like every one of the clients or expressed benchmark. Everyone has an alternate approach to responding to an enhancement presented. In this manner, you might encounter somewhat postponed weight reduction results however they will be clear in nature.
Request Active Keto Gummies Ireland From - Official Site
In the real situation, the body targets glucose from starches to consume muscle to fat ratio. Nonetheless, this fat consuming recipe conveys a job inversion impact. It uses the fat layers to diminish body size and give you results with no aftereffects. It's an exceptionally significant enhancement for battling muscle versus fat that prevalently works on your wellbeing. Support your ketogenic diet with this equation And never fall back to those difficultWays of diminishing stoutness.
Active Keto Gummies IrelandUK has an exceptionally fascinating approach to diminishing body size. It up keeps with your standard timetable and gives sufficient energy consistently. It knows how to support the impact of ketosis and lessen over dietary problems. Likewise, dealing with food desires and producing adequate side consuming outcome is additionally conceivable normally and without any problem.
Active Keto Gummies Ireland Facebook Pages-
https://www.facebook.com/ActiveKetoGummiesOfIE/
https://www.facebook.com/ActiveKetoGummiesOfIreland/
https://www.facebook.com/ActiveKetoGummiesAtIreland/
https://www.facebook.com/ActiveKetoGummiesIrelandOfficial/
Active Keto Gummies Ireland Blogs-
https://active-keto-gummies-in-ireland.mystrikingly.com/
https://active-keto-gummies-in-ie.mystrikingly.com/
https://activeketogummiesinireland.mystrikingly.com/
https://activeketogummiesie.mystrikingly.com/
https://activeketogummiesireland8.godaddysites.com/
https://activeketogummiesie0.godaddysites.com/
https://activeketogummiesinireland.godaddysites.com/
https://activeketogummiesinie.godaddysites.com/
https://active-keto-gummies-ireland-38ef07.webflow.io/
https://active-keto-gummies-ie-2633ca.webflow.io/
https://activeketogummiesireland-f3c61f.webflow.io/
https://activeketogummiesie.webflow.io/
https://active-keto-gummies-in-ireland.company.site/
https://active-keto-gummies-in-ie.company.site/
https://activeketogummiesinireland.company.site/
https://activeketogummiesie.company.site/
https://healthcare24x7hrs.blogspot.com/2023/07/active-keto-gummies-ireland-ie-biggest.html
https://healthcare24x7hrs.blogspot.com/2023/07/active-keto-gummies-ireland-review.html
https://sites.google.com/view/active-keto-gummies-in-ireland/
https://sites.google.com/view/active-keto-gummies-ie/
https://colab.research.google.com/drive/1PzS3rpk6uDqgQ9y6HhrOlJ9cvNeAaCdy
https://colab.research.google.com/drive/1PI6F4KSq4sRzh8_3vgzwG_UBM64fS6O2
https://lookerstudio.google.com/u/0/reporting/fb47e4f7-af24-4da8-bf4b-924d324ebd3d/page/nv5WD
https://lookerstudio.google.com/u/0/reporting/bbe7b32e-85de-4104-bfff-62fad3d9c1c6/page/j05WD
https://groups.google.com/g/active-keto-gummies-ireland-buy/c/7WN4k0b-FsI
https://groups.google.com/g/active-keto-gummies-ie/c/INz_JL9zHlY
https://www.linkedin.com/events/activeketogummiesireland-fraudw7131584109293801472/
https://www.linkedin.com/events/maximumstrength-activeketogummi7131584803652452352/
Ketoxplode Gummies Ireland Facebook Pages-
https://www.facebook.com/KetoxplodeGummiesIreland/
https://www.facebook.com/KetoxplodeGummiesInIreland/
https://www.facebook.com/KetoxplodeGummiesIE/
https://www.facebook.com/KetoxplodeGummiesInIE/
https://www.facebook.com/KetoExplodeGummiesIreland/
https://www.facebook.com/KetoExplodeGummiesInIreland/
https://www.facebook.com/KetoExplodeGummiesIE/
https://www.facebook.com/KetoExplodeGummiesInIE/
Keto Explode Gummies Sweden Facebook Pages-
https://www.facebook.com/KetoExplodeGummiesSE/
https://www.facebook.com/KetoExplodeGummiesInSE/
https://www.facebook.com/KetoExplodeGummiesSweden/
https://www.facebook.com/KetoExplodeGummiesInSweden/
https://www.facebook.com/KetoXplodeGummiesInSE/
https://www.facebook.com/KetoXplodeGummiesSverige/
https://www.facebook.com/KetoXplodeGummiesInSweden/
https://www.facebook.com/KetoXplodeGummiesInSverige/
Good Keto ACV Gummies Facebook Pages-
https://www.facebook.com/GoodKetoACVGummiesInUS/
https://www.facebook.com/GoodKetoACVGummiesSale/
https://www.facebook.com/GoodKetoACVGummiesOfficial/
https://www.facebook.com/GoodKetoACVGummiesShop/
https://www.facebook.com/PfizerKetoGummiesUS/
https://www.facebook.com/PfizerKetoGummiesInUS/
https://www.facebook.com/PfizerKetoGummiesOfUS/
https://www.facebook.com/PfizerKetoGummiesAtUS/
Keto Chews ACV Gummies Facebook Pages-
https://www.facebook.com/KetoChewsACVGummiesUS/
https://www.facebook.com/TryKetoChewsACVGummies/
https://www.facebook.com/KetoChewsACVGummiesInUS/
https://www.facebook.com/KetoChewsACVGummiesOfUS/
https://www.facebook.com/KetoChewsACVGummiesAtUS/
https://www.facebook.com/TrySerenaLeafzCBDGummiesInCA/
https://www.facebook.com/TrySerenaLeafzCBDGummiesCanada/